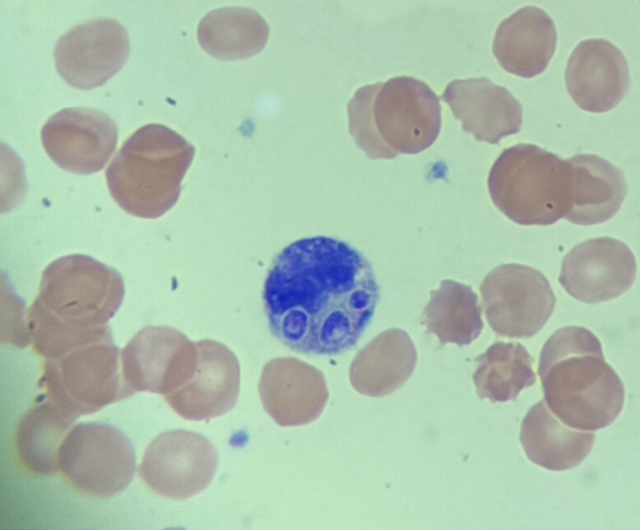
Inpatient Heme Consult: Young pt, limited medical care prior.  some DIC labs positive - rectal bleeding from ulcerative lesion.  Systemic adenopathy suspicious for lymphoma.  LDH very high.  HIV prelim positive.  You see this on smear - diagnosis?
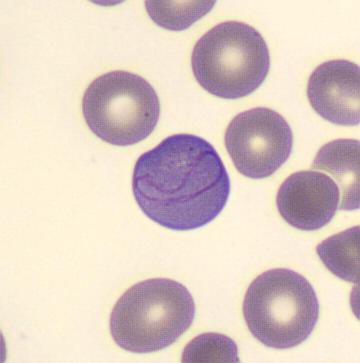
Blood smear of a vegan.

What do you see❓️

What do you say❓️

Parnaz Danesh
@paeanox
Hemepath Fellow @stanfordpath | Secretary at CAP RFEC @pathologists | Pathology Chief Resident @pennmedicine | Postdoc Fellow @hopkinsmedicine
ID: 599263277
https://scholar.google.com/citations?user=d_hebtwAAAAJ&hl=en&oi=ao 04-06-2012 13:58:44
581 Tweet
1,1K Takipçi
847 Takip Edilen

















So excited to see this work published! Grateful to have been part of this team studying PDC proliferations and their prognostic relevance in CMML. #hemePath #CMML #pathX Penn Path & Lab Medicine

Thrilled to Welcome Parnaz Danesh and Siddharth Moturi to Hurone AI - Kingsley I. Ndoh oncodaily.com/voices/kingsle… #Cancer #Medicine #Health #Oncology #OncoDaily #MedX #MedNews #MedEd